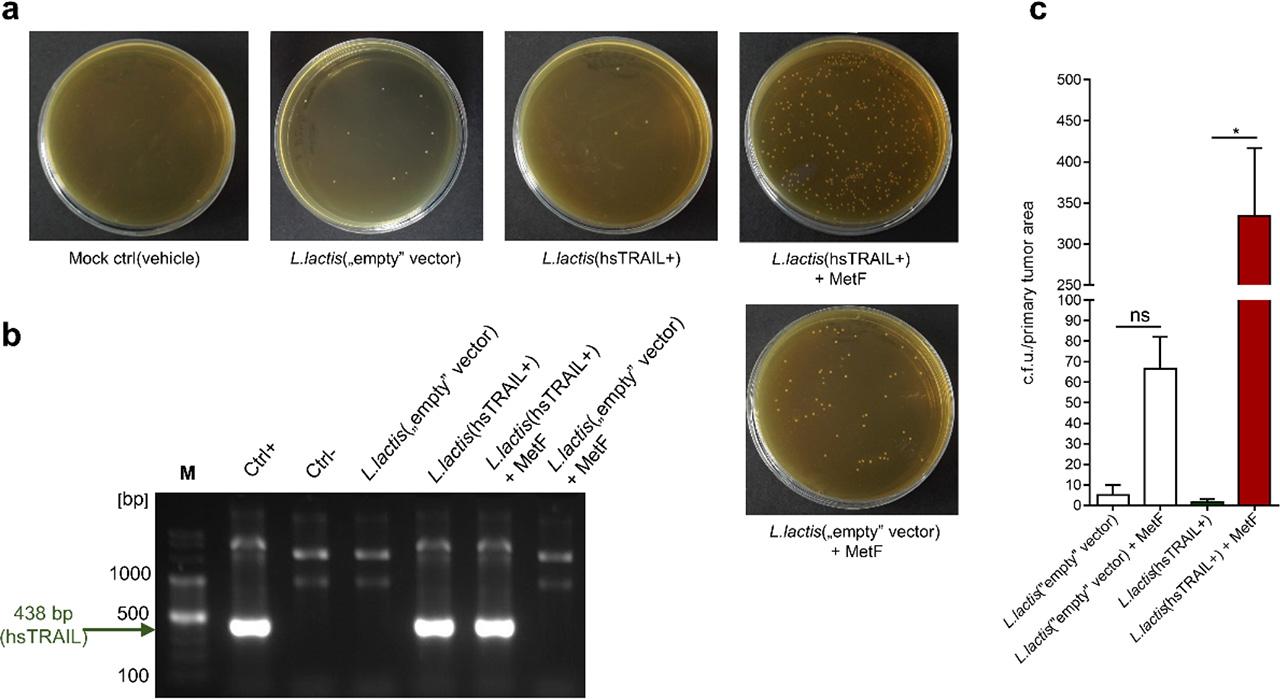

Fig 1.

Fig 2.

Fig 3.

Fig 4.

Fig 5.

Fig 6.

© 2024 Katarzyna Kaczmarek, Jerzy Więckiewicz, Ivo Que, Adrianna Gałuszka-Bulaga, Alan Chan, Maciej Siedlar, Jarek Baran, published by Hirszfeld Institute of Immunology and Experimental Therapy
This work is licensed under the Creative Commons Attribution-NonCommercial-NoDerivatives 4.0 License.